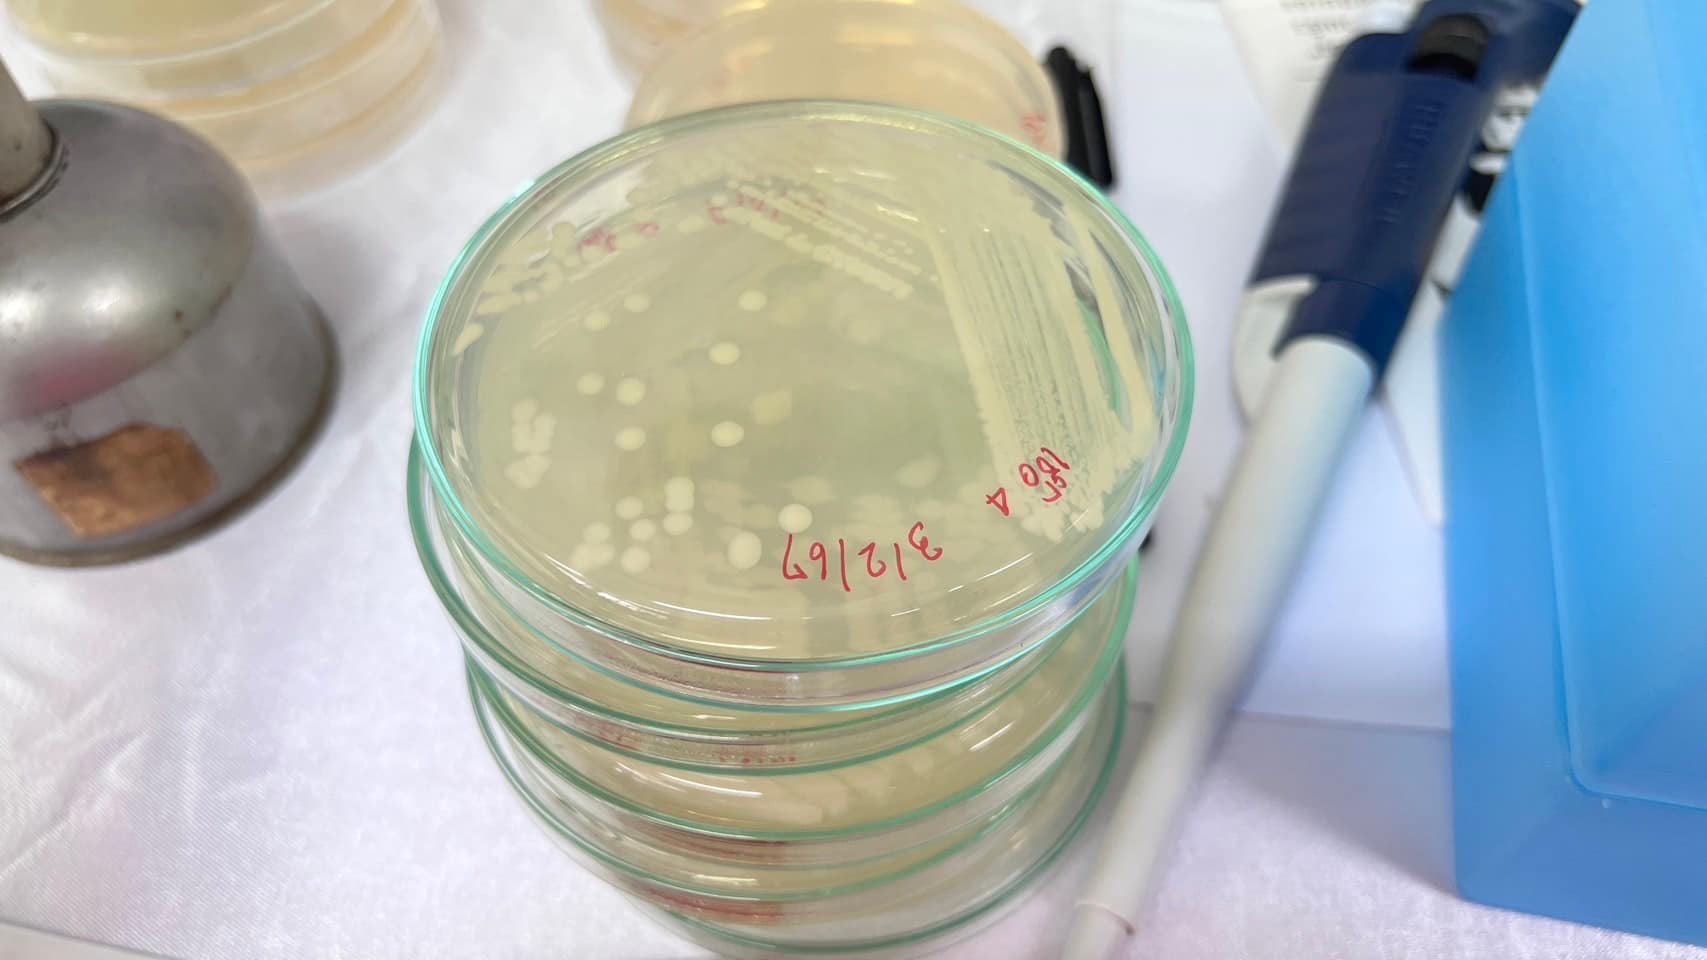

เมื่อวันที่ 3 กุมภาพันธ์ 2567 รศ.ดร. สุธัญญา พรหมสมบูรณ์ คณบดีคณะวิทยาศาสตร์และเทคโนโลยี มหาวิทยาลัยเทคโนโลยีราชมงคลตะวันออก เป็นประธานเปิดโครงการพัฒนาระบบการบริหารจัดการเทคโนโลยี นวัตกรรม และทรัพย์สินทางปัญญาเพื่อเตรียมความพร้อมต่อยอดสู่เขิงพาณิชย์ โครงการย่อยที่ 5 การถ่ายทอดเทคโนโลยีการผลิตปุ๋ยหมักอินทรีย์ชีวภาพแบบไม่กลับกอง และปุ๋ยอัดเม็ดเสริมภูมิต้านทานพืช จากวัสดุเหลือใช้ทางการเกษตร กิจกรรมที่ 1 อบรมการปฏิบัติการทำปุ๋ยหมักอินทรีย์ชีวภาพแบบไม่กลับกอง และปุ๋ยอัดเม็ดเสริมภูมิต้านทานพืช จากวัสดุเหลือใช้ทางการเกษตร ที่จัดขึ้นระหว่าง 3 -4 กุมภาพันธ์ 2567 โดยมี ผศ.ดร. กรณัฏฐ์ นาคภิบาล รองคณบดีฝ่ายวิชาการและวิจัย กล่าวรายงานถึงวัตถุประสงค์การจัดงาน ที่จัดขึ้นเพื่อถ่ายทอดเทคโนโลยีการผลิตปัจจัยการผลิตทางการเกษตรจากวัสดุเหลือใช้


ซึ่งได้รับเกียรติจาก คุณจุฑารัตน์ กุลศิริวนิชย์ รักษาการผู้อำนวยการกลุ่มควบคุมปุ๋ย และ คุณศิริชัย ถาวร นักวิชาการเกษตร ระดับ ชำนาญการพิเศษ สังกัด กลุ่มควบคุมวัตถุอันตราย สำนักควบคุมพืชและวัสดุการเกษตร กรมวิชาการเกษตร บรรยายในหัวข้อเรื่อง บทสรุปพระราชบัญญัติปุ๋ย พ.ศ. 2518 แก้ไขเพิ่มเติมโดย พระราชบัญญัติปุ๋ย การขออนุญาตประกอบกิจการปุ๋ยเพื่อการค้า การขอขึ้นทะเบียน หรือ การรับแจ้งปุ๋ย และการขึ้นทะเบียนวัตถุอันตรายและสารชีวภัณฑ์


อาจารย์ ดร.วัชรินทร์ ยุทธวานิชกุล อาจารย์มนตรี เรืองสิงห์ อาจารย์จินตนา เพชรมณีโชติ และอาจารย์ ดร. สุธีรา อานามวงษ์ วิทยากรจากสาขาวิชาเทคโนโลยีชีวภาพ บรรยายและปฏิบัติการ เรื่อง การทำสารชีวภัณฑ์ที่ใช้ทางการเกษตร และการผลิตปุ๋ยอินทรีย์ การผลิตปุ๋ยชีวภาพปุ๋ยอินทรีย์แบบไม่กลับกอง : วิศวกรรมแม่โจ้



ทั้งนี้มีผู้สนใจโดยเป็นบุคคลทั่วไป เกษตรกร วิสาหกิจชุมชน นักวิจัย นักศึกษาปริญญาโท และศิษย์เก่า เข้าอบรมกว่า 40 คน